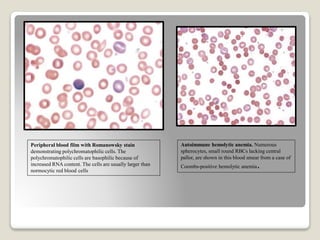
Peripheral blood film with Romanowsky stain
demonstrating polychromatophilic cells. The
polychromatophilic cells are basophilic because of
increased RNA content. The cells are usually larger than
normocytic red blood cells
Autoimmune hemolytic anemia. Numerous
spherocytes, small round RBCs lacking central
pallor, are shown in this blood smear from a case of
Coombs-positive hemolytic anemia.

Hereditary spherocytosis is a hereditary hemolytic anemia caused by a red blood cell membrane defect that results in spherocytosis. The misshapen red blood cells, called spherocytes, are destroyed by the spleen, leading to hemolysis and a shortage of red blood cells. Clinical features include jaundice, splenomegaly, and gallstones. Laboratory findings show microspherocytes on peripheral blood film and increased reticulocytes, with normal red blood cell size.